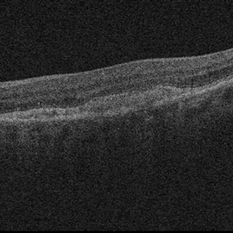
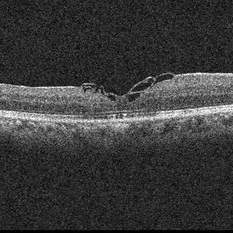
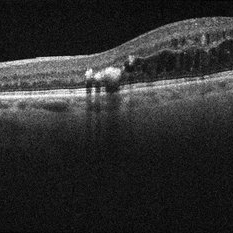

-
 Aquired Vitelliform Maculopathy
Aquired Vitelliform Maculopathy
Jun 29 2014 by John S. King, MD
Asymptomatic MA healthy female consulted for wet AMD. Plan: observe. Photo and AF initially and year afterwards. Health MA female; no vitritis or other lesions; similar findings in both eyes.
Photographer: Wayne A Ladlee Jr
Condition/keywords: aquired vitelliform maculopathy
-
Aquired Vitelliform Maculopathy
Aquired Vitelliform Maculopathy
Jun 29 2014 by John S. King, MD
Initial presentation.
Photographer: Wayne A Ladlee Jr
Imaging device: Cirrus
Condition/keywords: aquired vitelliform maculopathy
-
 AVM 2
AVM 2
Jun 29 2014 by John S. King, MD
Atrophy of lesion with observation.
Photographer: Wayne A Ladlee Jr
Imaging device: Cirrus
Condition/keywords: aquired vitelliform maculopathy
-
 Ushers 2
Ushers 2
Jun 29 2014 by John S. King, MD
Ushers 2
Photographer: Wayne A Ladlee Jr
Condition/keywords: usher's syndrome
-
 Ushers 2
Ushers 2
Jun 29 2014 by John S. King, MD
Ushers 2.
Photographer: Wayne A Ladlee Jr
Imaging device: Cirrus
Condition/keywords: usher's syndrome
-
 BSCR/HLA-A29+
BSCR/HLA-A29+
Jul 1 2014 by John S. King, MD
BSCR/HLA-A29+, MA male, photopsia on p/c, small hypopigmented round to oval lesions mainly peripapillary and inf-nasal to nerve, controlled on cellcept and cyclosporine.
Photographer: Wayne A Ladlee Jr
Condition/keywords: birdshot chorioretinopathy
-
 Preretinal Triamcinolone Crystals Years after IVT
Preretinal Triamcinolone Crystals Years after IVT
Jun 8 2016 by John S. King, MD
Preretinal crystals years after IVT.
Condition/keywords: crystalline retinopathy, crystals
-
 Congenital Simple Hemartoma of the RPE
Congenital Simple Hemartoma of the RPE
Jun 8 2016 by John S. King, MD
Congenital simple hamartoma of the RPE.
Condition/keywords: hamartoma, retinal pigment epithelium
-
 IIH-Pre-Shunt
IIH-Pre-Shunt
Jun 8 2016 by John S. King, MD
Prior to vp-shunt.
Condition/keywords: idiopathic intracranial hypertension, pseudotumor cerebri
-
 IIH-Post-Tx
IIH-Post-Tx
Jun 8 2016 by John S. King, MD
One month post vp-shunt.
Condition/keywords: idiopathic intracranial hypertension, pseudotumor cerebri
-
 Macular Hole POD 1 OCT
Macular Hole POD 1 OCT
Jun 21 2016 by John S. King, MD
POD 1 - hole closed as seen on OCT
Condition/keywords: full thickness macular hole, optical coherence tomography (OCT)
-
 Schlaegel Lines in MCP
Schlaegel Lines in MCP
Jun 27 2016 by John S. King, MD
13-year-old African American female moved here recently - difficulty with recent school eye exam - healthy
Condition/keywords: multifocal chorioretinitis (MCP)
-
 Myelinated NFL
Myelinated NFL
Dec 2 2017 by John S. King, MD
Myelinated NFL.
Imaging device: Topcon
Condition/keywords: myelinated nerve fiber layer, myelinated nerve fibers
-
 Myelinated NFL
Myelinated NFL
Dec 6 2017 by John S. King, MD
Myelinated NFL.
Imaging device: Topcon
Condition/keywords: background diabetic retinopathy (BDR), myelinated nerve fiber layer, myelinated nerve fibers
-
 PDR with NVD and CRVO history
PDR with NVD and CRVO history
Dec 6 2017 by John S. King, MD
One year earlier she had a CRVO with lots of CME, treated once with avastin, and scheduled to be seen and treated a month later; at that time no nv and some cap dropout seen in FAZ area, but extent of dropout limited by heme, diffuse cme, and no wide field image at that time; lost to follow up until a year later; see above
Imaging device: Optos
Condition/keywords: central retinal vein occlusion (CRVO), diabetic retinopathy
-
 Halo Nevus
Halo Nevus
-
 Stickler
Stickler
Dec 13 2017 by John S. King, MD
10-year-old hx SB 2014 and some laser for peripheral changes in the meantime. Mother has hx of bil GRTs. Seen over the weekend; when I saw her in OR there were multiple tears periph, and superior macula off RD. During surgery there was questionable MH (but view limited some by prior PSC). Peeled macula. Left Sil Oil 1000cs.
Imaging device: optos
Condition/keywords: Stickler Syndrome
-
 POHS-CNVM
POHS-CNVM
Jan 7 2018 by John S. King, MD
17-year-old hx scotoma a year ago; 1-2 months of worsening scotoma; small chorio-retinal punched out lesions in mid-periph; midperipheral curvilinear pigment band in inf 180 degrees; staining and leakage on FA; avastin administered.
Imaging device: Topcon
Condition/keywords: choroidal neovascular membrane (CNVM), presumed ocular histoplasmosis syndrome (POHS)
-
 OHS-CNVM
OHS-CNVM
Jan 7 2018 by John S. King, MD
17-year-old hx scotoma a year ago; 1-2 months of worsening scotoma; small cr punched out lesions in mid-periph; midperipheral curvilinear pigment band in inf 180 degrees.
Imaging device: topcon
Condition/keywords: choroidal neovascular membrane (CNVM), ocular histoplasmosis syndrome (OHS)
-
 Nasal Choroidal Mass
Nasal Choroidal Mass
Jan 7 2018 by John S. King, MD
Mets vs Melanoma
Imaging device: Optos
Condition/keywords: choroidal mass
-
 Retinal Tear
Retinal Tear
Jan 8 2018 by John S. King, MD
Acute floaters/photopsias
Imaging device: Optos
Condition/keywords: bridge of tissue between tears, full thickness retinal tear
-
 Optic Nerve Edema
Optic Nerve Edema
Jan 9 2018 by John S. King, MD
Optic Nerve Edema
Imaging device: Topcon
Condition/keywords: optic nerve edema
-
 Optic Nerve Edema
Optic Nerve Edema
Jan 9 2018 by John S. King, MD
Optic Nerve Edema
Imaging device: Topcon
Condition/keywords: optic nerve edema
-
 Optic Nerve Edema
Optic Nerve Edema
Jan 9 2018 by John S. King, MD
Optic Nerve Edema
Imaging device: Topcon
Condition/keywords: optic nerve edema
-
 Optic Nerve Edema
Optic Nerve Edema
Jan 9 2018 by John S. King, MD
Optic Nerve Edema
Imaging device: Topcon
Condition/keywords: optic nerve edema
-
 ONE-NFL
ONE-NFL
Jan 9 2018 by John S. King, MD
Optic nerve edema, nerve fiber layer
Imaging device: Cirrus
Condition/keywords: optic nerve edema
-
 Collateral Vessels in Resolved HRVO
Collateral Vessels in Resolved HRVO
Feb 12 2018 by John S. King, MD
Initial presentation: 25-year-old AAM; Hx DM, Sarcoidosis, Renal Disease, HTN with recent hypertensive crisis. Collateral vessels likely due to old HRVO with one front of NVE inferiorly; veins attenuated proximal to the collateral vessels.
Condition/keywords: collaterals, hemicentral retinal vein occlusion, retinal neovascularization
-
 AMD With Calcified Drusen and Small, Deep IRH
AMD With Calcified Drusen and Small, Deep IRH
Jul 22 2018 by John S. King, MD
AMD with calcified drusen and small, deep IRH
Photographer: Stacey
Imaging device: Topcon
Condition/keywords: calcified drusen
-
 CSCR with PED Defect
CSCR with PED Defect
Sep 3 2018 by John S. King, MD
Acute symptoms; HTN retinopathy and recent high BP readings; Hodgkins lymphoma (stable > 10 yrs), diabetic.
Photographer: Stacey Coleman
Imaging device: Cirrus
Condition/keywords: central serous chorioretinopathy (CSCR), pigment epithelial detachment (PED)
-
 CSCR with PED Defect
CSCR with PED Defect
Sep 3 2018 by John S. King, MD
Acute symptoms; no steroids; HTN retinopathy and recent high BP readings; Hodgkins lymphoma (stable > 10 yrs), diabetic.
Photographer: Stacey Coleman
Imaging device: Cirrus
Condition/keywords: central serous chorioretinopathy (CSCR), pigment epithelial detachment (PED)
-
 Proliferative Sickle Retinopathy
Proliferative Sickle Retinopathy
Sep 4 2018 by John S. King, MD
Initial picture before Dr. Hruby performed laser. Peripheral ischemia and some "sea fan" retinal neovascularization present.
Photographer: Pam Hall
Imaging device: Optos CA
Condition/keywords: proliferative retinopathy, sickle cell retinopathy
-
 Proliferative Sickle Retinopathy
Proliferative Sickle Retinopathy
Sep 4 2018 by John S. King, MD
Initial photo (left) and 4 months after Dr. Hruby performed peripheral circumferential retinal scatter photocoagulation to zone of peripheral ischemia (right). Regression of neovascularization.
Photographer: Stacey
Imaging device: Optos CA
Condition/keywords: laser photocoagulation, proliferative retinopathy, sickle cell retinopathy
-
 NAION, ERM
NAION, ERM
Sep 7 2018 by John S. King, MD
70-year-old white male with background history of fovea involving RD repaired with PPV 5 months ago, and history of HTN. Some recent photopsias, mild scotoma. Focal ERM superiorly and swollen superior part of the optic disc.
Photographer: Macey
Imaging device: Topcan
Condition/keywords: drusen, epiretinal membrane (ERM), ischemic optic neuropathy
-
 NAION, ERM
NAION, ERM
Sep 7 2018 by John S. King, MD
70-year-old white male with background history of fovea involving RD repaired with PPV 5 months ago, and history of HTN. Some recent photopsias, mild scotoma. Focal ERM superiorly and swollen superior part of the optic disc.
Photographer: Macey
Imaging device: Topcon
Condition/keywords: drusen, epiretinal membrane (ERM), ischemic optic neuropathy
-
 Optos Picture With Speculum: Dislocated Natural Lens
Optos Picture With Speculum: Dislocated Natural Lens
Oct 9 2018 by John S. King, MD
55-year-old white female with history of pathologic myopia+, lattice (laser), SB OU (1990s), and dislocated natural lenses OU that had been watched for years. In the fellow eye she developed phacolytic glaucoma and a PPV, PPL was performed. Plan for both eyes are monitoring. I wanted to get a good picture of her lens today with the optos machine, as the other pics had artifact from the lower lid. It worked out well to use a speculum in the left eye. Vision cc is 20/400 J1+ OD and 20/40 J2 OS; aphakic OU; vitreous clear OD; dislocated lens OS (see pic); retinas attached.
Photographer: Maisee Yang
Imaging device: Optos California
Condition/keywords: dislocated crystalline lens, pathologic myopia, scleral buckle, staphyloma
-
 Reticular Drusen
Reticular Drusen
Dec 5 2018 by John S. King, MD
82-year-old white female asymptomatic OD (20/25); new CNVM in fellow eye. Also mild ERM and an aquired vitelliform like lesion centrally.
Photographer: Maisee Yang
Imaging device: Topcon
Condition/keywords: reticular drusen
-
 RAMA
RAMA
Dec 5 2018 by John S. King, MD
Person I saw in follow up. Been monitored. Multilayered heme resolving and hard exudates after RAMA.
Imaging device: Topcon
Condition/keywords: ruptured macroaneurysm
-
 Weiss Ring
Weiss Ring
Jan 9 2019 by John S. King, MD
77-year-old white male with ERM and PVD OD; sheet of vitreous with weiss ring in the nasal mid-vitreous cavity.
Photographer: Macey Highfill, RN
Imaging device: Topcon 50
Condition/keywords: posterior vitreous detachment, Weiss ring
-
 Weiss Ring
Weiss Ring
Jan 9 2019 by John S. King, MD
77-year-old white male with ERM and PVD OD; sheet of vitreous with weiss ring in the nasal mid-vitreous cavity.
Photographer: Macey Highfill, RN
Imaging device: Topcon 50
Condition/keywords: posterior vitreous detachment, Weiss ring
-
 Orange Pigment Overlying a Lesion Suspicious for a Choroidal Melanoma
Orange Pigment Overlying a Lesion Suspicious for a Choroidal Melanoma
Jan 16 2019 by John S. King, MD
76-year-old white male saw his eye doctor with a three week complaint of photopsias and a shadow in his vision. Found to have a 10.5/12.5/2.5 (medium reflectivity) pigmented, choroidal mass associated with SRF and orange pigment (hyper-autofluorescence of lipofuscin), and without drusen or halo. See photo
Photographer: Stacey Coleman
Imaging device: Topcon 50
Condition/keywords: lipofuscin, orange pigment
-
 Hyper-autofluorescence of Orange Pigment Overlying a Lesion Suspicious for a Choroidal Melanoma
Hyper-autofluorescence of Orange Pigment Overlying a Lesion Suspicious for a Choroidal Melanoma
Jan 16 2019 by John S. King, MD
76-year-old white male saw his eye doctor with a three week complaint of photopsias and a shadow in his vision. Found to have a 10.5/12.5/2.5 (medium reflectivity) pigmented, choroidal mass associated with SRF and orange pigment (hyper-autofluorescence of lipofuscin, see image), and without drusen or halo.
Photographer: Stacey Coleman
Imaging device: Topcon 50
Condition/keywords: lipofuscin, orange pigment
-
 Optic Nerve Melanocytoma
Optic Nerve Melanocytoma
May 27 2019 by John S. King, MD
56 year-old African American female, asymptomatic, sent to Dr. Medlock to rule out a melanoma; 20/20 without an APD.
Imaging device: Topcon
Condition/keywords: optic disc melanocytoma
-
 Atypical Midperipheral Lesion that Looks Similar to Torpedo Maculopathy
Atypical Midperipheral Lesion that Looks Similar to Torpedo Maculopathy
May 27 2019 by John S. King, MD
14-year-old African American female who is asymptomatic, without any hx/fhx of FAP. One lesion seen in the mid-periphery of the right eye that is oval in shape, and has a "tail" (points to ora), and has the appearance and size of lesions described by Dr. Shields as torpedo maculopathy. I did ask Dr. Carol Shields about the case, and she said it is possible that this is a similar lesion in an odd location and noted that Gass published on one superiorly.
Photographer: Shelly Blair
Imaging device: Optos CA
Condition/keywords: torpedo maculopathy
-
 Acute Optic Neuropathy Due to Large Mucocele (Incidental Bear Tracks)
Acute Optic Neuropathy Due to Large Mucocele (Incidental Bear Tracks)
Jun 1 2019 by John S. King, MD
84-year-old white female with acute loss of vision in the left eye one day ago was sent here after going to the ED per primary eye provider. She described vision loss as a grey curtain that became total darkness. She had left sided temporal tenderness and some left sided neck pain. In the ED the cardiac work-up was u/r, the ESR and CRP were normal, and the CTH showed some non-specific opacification in the L ethmoid sinus. Acuity was HM OS with RAPD, normal EOMs, no proptosis or ptosis, posteriorly no SVPs were noted; the optic discs were pink and flat; no emboli or retinal whitening present; some bear tracks located nasally (see photo). She was referred to Dr. Doyle, who ordered an MRI, which showed a large mucocele with bony erosion into the left orbit, along with some ON enhancement possibly from compression (see images). She was operated that night and later recovered to 20/40 in that eye with a residual, inferior arcuate scotoma.
Photographer: Karin Aletter
Imaging device: Topcon 50
Condition/keywords: bear tracks, optic neuropathy
-
 Acute Optic Neuropathy Due to Large Mucocele
Acute Optic Neuropathy Due to Large Mucocele
Jun 1 2019 by John S. King, MD
84-year-old white female with acute loss of vision in the left eye one day ago was sent here after going to the ED per primary eye provider. She described vision loss as a grey curtain that became total darkness. She had left sided temporal tenderness and some left sided neck pain. In the ED the cardiac work-up was u/r, the ESR and CRP were normal, and the CTH showed some non-specific opacification in the L ethmoid sinus. Acuity was HM OS with RAPD, normal EOMs, no proptosis or ptosis, posteriorly no SVPs were noted; the optic discs were pink and flat; no emboli or retinal whitening present; some bear tracks located nasally (see photo). She was referred to Dr. Doyle, who ordered an MRI, which showed a large mucocele with bony erosion into the left orbit, along with some ON enhancement possibly from compression (see Images). She was operated that night and later recovered to 20/40 in that eye with a residual, inferior arcuate scotoma.
Condition/keywords: bear tracks, optic neuropathy
-
 Acute Compressive Optic Neuropathy
Acute Compressive Optic Neuropathy
Jun 1 2019 by John S. King, MD
84-year-old white female with acute loss of vision in the left eye one day ago was sent here after going to the ED per primary eye provider. She described vision loss as a grey curtain that became total darkness. She had left sided temporal tenderness and some left sided neck pain. In the ED the cardiac work-up was u/r, the ESR and CRP were normal, and the CTH showed some non-specific opacification in the L ethmoid sinus. Acuity was HM OS with RAPD, normal EOMs, no proptosis or ptosis, posteriorly no SVPs were noted; the optic discs were pink and flat; no emboli or retinal whitening present; some bear tracks located nasally (see photo). She was referred to Dr. Doyle, who ordered an MRI, which showed a large mucocele with bony erosion into the left orbit, along with some ON enhancement possibly from compression (see images). She was operated that night and later recovered to 20/40 in that eye with a residual, inferior arcuate scotoma.
Condition/keywords: bear tracks, optic neuropathy
-
 Traumatic Pseudohole with Commotio Retinae and Subfoveal Hemorrhage after Blunt Injury
Traumatic Pseudohole with Commotio Retinae and Subfoveal Hemorrhage after Blunt Injury
Jun 1 2019 by John S. King, MD
39-year-old African American female with central scotoma two days since blunt head injury in MVA, sent for evaluation of macular hole. 20/150 OS with IOP 12 and no RAPD. No macular hole present. Macular findings include commotio retinae and subfoveal hemorrhage.
Photographer: Stacey Coleman
Imaging device: Topcon
Condition/keywords: blunt trauma, commotio retinae, macular pseudohole, subretinal hemorrhage
-
 Multiple Areas of Myelinated RNFL OD
Multiple Areas of Myelinated RNFL OD
Sep 18 2019 by John S. King, MD
68-year-old African American male presented with an acute PVD in the fellow eye. Fellow eye had similar findings, but the pics were not as good as OD.
Photographer: Brittany Dewberry
Imaging device: Optos CA
Condition/keywords: myelinated nerve fiber layer, myelinated nerve fibers
-
 Dry AMD with Central Geographic Atrophy, a Few Intraretinal Crystals, and Prominent Choroidal Vessels
Dry AMD with Central Geographic Atrophy, a Few Intraretinal Crystals, and Prominent Choroidal Vessels
Sep 18 2019 by John S. King, MD
93-year-old white female routine AMD visit with VA of CF in OD due to central geographic atrophy.
Photographer: Gretchen Harper
Imaging device: Topcon 50
Condition/keywords: crystalline retinopathy, dry, geographic atrophy
-
 Subretinal Fibrosis (PPCNVM and POHS) OS
Subretinal Fibrosis (PPCNVM and POHS) OS
Sep 18 2019 by John S. King, MD
57-year-old white male with history of PPCNVM OS and POHS OU here for a routine visit. History of avastin in 2014, and stable since then. Va OS 20/20. PP scar with macular subretinal fibrosis. No heme or exudates. CR spot supero-nasally.
Photographer: Shelly Blair
Imaging device: Topcon 50
Condition/keywords: choroidal neovascular membrane (CNVM), ocular histoplasmosis syndrome (OHS), peripapillary choroidal neovascularization (PPCNVM), presumed ocular histoplasmosis syndrome (POHS)
-
 Massive SRH in Patient on Coumadin Being Treated for Exudative AMD
Massive SRH in Patient on Coumadin Being Treated for Exudative AMD
Sep 30 2019 by John S. King, MD
78-year-old white female using 1mg of warfarin for atrial fibrillation, who had a large PED, Type 1 lesion from AMD. Noticed acute darkening of vision one week after anti-VEGF injection. Has very large SRH, subRPE heme, and corrugated retinal appearance post RPE tear. Vision HM (from 20/100). 20/25 in the fellow eye that has dry AMD.
Photographer: Shelly Blair
Imaging device: Optos CA
Condition/keywords: subretinal hemorrhage, wet age-related macular degeneration (wet AMD)
-
 Choroidal Metastasis from Breast Cancer
Choroidal Metastasis from Breast Cancer
Oct 1 2019 by John S. King, MD
60-year-old white female with four year history of breast cancer associated with metastasis to many organs including the CNS, was sent her to r/o melanoma, found on routine exam. Visual acuity was HM; there was NSC/PSC; there was a unilateral, large choroidal lesion in the posterior pole that was yellow, well circumscribed, with plateau configuration associated with SRF adn heme.
Photographer: Kay Dalby
Imaging device: Optos CA
Condition/keywords: breast cancer, choroidal lesions, choroidal metastasis
-
 Choroidal Metastasis from Breast Cancer
Choroidal Metastasis from Breast Cancer
Oct 1 2019 by John S. King, MD
60-year-old white female with four year history of breast cancer associated with metastases to many organs including the CNS, was sent her to r/o melanoma, found on routine exam. Visual acuity was HM; there was NSC/PSC; there was a unilateral, large choroidal lesion in the posterior pole that was yellow, well circumscribed, with plateau configuration associated with SRF adn heme.
Photographer: Kay Dalby
Imaging device: Optos CA
Condition/keywords: breast cancer, choroidal lesions, choroidal metastasis
-
 Peripheral CNVM with Extensive Scarring
Peripheral CNVM with Extensive Scarring
Oct 12 2019 by John S. King, MD
82-year-old white male with an acute loss of vision in the right eye was sent in to rule out a retinal detachment. Vision was 20/350; a dense VH was present, b-scan showed irregular areas of high reflectivity in the periphery that was c/w SRH. Peripherally, a few weeks later, there were areas that could be seen and were c/w peripheral CNVM (old and new). Anti-VEGF was administered. A month later vision was unchanged and patient wanted surgery to remove the VH. Pictured is one week since surgery; large peripheral scars are seen; diffuse areas of SR pigmentation is present; vitreous skirt present; and a few IRHs secondary to DR can be seen. He is currently 20/70 sc.
Photographer: Shelly Blair
Imaging device: Optos CA
Condition/keywords: choroidal neovascular membrane (CNVM), peripheral fundus lesion, vitreous blood
-
7 Months Post-MH Repair Using Petalloid ILM Flap
7 Months Post-MH Repair Using Petalloid ILM Flap
Nov 6 2019 by John S. King, MD
68-year-old African American male with history of poor vision in the right eye, at least three weeks, was found to have a large macular hole (about 900 micron thickness), and VMT "hinge." Vision CF 2 ft with 1-2+ NSC. ILM was peeled and a petalloid type ILM flap was used along with viscoat to help keep tissue in place. 7 months later is 20/50 with a closed hole and residual, stringy like ILM remnants in the foveal region.
Imaging device: Cirrus - Macular Scan
Condition/keywords: full thickness macular hole, ILM flap
-
 Comparison Before and After Treatment of Large Macular Hole Using a Petalloid ILM Flap
Comparison Before and After Treatment of Large Macular Hole Using a Petalloid ILM Flap
Nov 6 2019 by John S. King, MD
68-year-old African American male with history of poor vision in the right eye, at least three weeks, was found to have a large macular hole (about 900 micron thickness), and VMT "hinge." Vision CF 2 ft with 1-2+ NSC. ILM was peeled and a petalloid type ILM flap was used along with viscoat to help keep tissue in place. 7 months later is 20/50 with a closed hole and residual, stringy like ILM remnants in the foveal region.
Imaging device: Cirrus
Condition/keywords: ILM flap, macular hole
-
 Photo of Large Hemorrhage with macular detachment due to AMD
Photo of Large Hemorrhage with macular detachment due to AMD
Nov 7 2019 by John S. King, MD
81-year-old white female with three day history of seeing a "dark blob" nasally OD; no blood thinners; vision was 20/100- J16 with 2+NSC OD; OCT (not shown) had large SRF that included the fovea and extended out temporally. Posterior segment showed a large amount of SRF in the macula with some SRH in the inferior portion of the macula, hemorrhagic PEDs temporally with some RPE scarring and SRH in the periphery. On the FA there is blockage by the SRH and SRPE heme; there is staining peripherally; there is a wavbe of leakage that extends out into the macula and pools into to subretinal space. Anti-VEGF given; f/u one month.
Photographer: Brandon Peter
Condition/keywords: retinal pigment epithelium, subretinal hemorrhage, wet age-related macular degeneration (wet AMD)
-
 FA 5 min - Large Hemorrhage With Macular Detachment Due to AMD
FA 5 min - Large Hemorrhage With Macular Detachment Due to AMD
Nov 7 2019 by John S. King, MD
81-year-old white female with three day history of seeing a "dark blob" nasally OD; no blood thinners; vision was 20/100- J16 with 2+NSC OD; OCT (not shown) had large SRF that included the fovea and extended out temporally. Posterior segment showed a large amount of SRF in the macula with some SRH in the inferior portion of the macula, hemorrhagic PEDs temporally with some RPE scarring and SRH in the periphery. On the FA there is blockage by the SRH and SRPE heme; there is staining peripherally; there is a wavbe of leakage that extends out into the macula and pools into to subretinal space.
Photographer: Brandon Peter
Condition/keywords: retinal pigment epithelium, subretinal hemorrhage, wet age-related macular degeneration (wet AMD)
-
 FA 40 Seconds - Large Hemorrhage With Macular Detachment Due to AMD
FA 40 Seconds - Large Hemorrhage With Macular Detachment Due to AMD
Nov 7 2019 by John S. King, MD
81-year-old white female with three day history of seeing a "dark blob" nasally OD; no blood thinners; vision was 20/100- J16 with 2+NSC OD; OCT (not shown) had large SRF that included the fovea and extended out temporally. Posterior segment showed a large amount of SRF in the macula with some SRH in the inferior portion of the macula, hemorrhagic PEDs temporally with some RPE scarring and SRH in the periphery. On the FA there is blockage by the SRH and SRPE heme; there is staining peripherally; there is a wave of leakage that extends out into the macula and pools into to subretinal space.
Photographer: Brandon Peter
Condition/keywords: retinal pigment epithelium, subretinal hemorrhage, wet age-related macular degeneration (wet AMD)
-
 Diabetic TRD - Photos OS
Diabetic TRD - Photos OS
Nov 17 2019 by John S. King, MD
28-year-old white male with poorly controlled Type 1 DM, with a history of non-compliance with follow-ups, was referred with for DR with CME OS, and 3 weeks decrease vision OS. Va cc was 20/15 OD and HM OS. IOP 18/14. No NVI OU. Posteriorly, the right eye had macular exudates, no NVD, and a large area of NVE along the IT arcade. The left eye large NV plaque around disc, wrapping macula, with total RD with a posterior funnel appearance. The FA in the left eye showed severe peripheral and macular ischemia with diffuse leakage from a fibrovascualr plaque.
Photographer: Adriana Shelby
Imaging device: Optos CA
Condition/keywords: diabetic traction detachment, open funnel RD
-
 Diabetic TRD OS - FA 1 Min
Diabetic TRD OS - FA 1 Min
Nov 17 2019 by John S. King, MD
28-year-old white male with poorly controlled Type 1 DM, with a history of non-compliance with follow-ups, was referred with for DR with CME OS, and 3 weeks decrease vision OS. Va cc was 20/15 OD and HM OS. IOP 18/14. No NVI OU. Posteriorly, the right eye had macular exudates, no NVD, and a large area of NVE along the IT arcade. The left eye large NV plaque around disc, wrapping macula, with total RD with a posterior funnel appearance. The FA in the left eye showed severe peripheral and macular ischemia with diffuse leakage from a fibrovascualr plaque.
Photographer: Adriana Shelby
Imaging device: Optos CA
Condition/keywords: diabetic traction detachment, open funnel RD
-
 CSCR
CSCR
Apr 22 2020 by John S. King, MD
35-year-old healthy African American male with five days of acute distortion and noticing a round halo when closing eyes. Yellowish area are cluster of PEDs without any SR exudate. 20/50, normotensive, exam u/r except for the macular SRF (see photo). Monitoring.
Photographer: Kay Dalby
Imaging device: Topcon
Condition/keywords: central serous chorioretinopathy (CSCR)
-
 PPCNVM and Peripheral Drusen Seen on Optos FA
PPCNVM and Peripheral Drusen Seen on Optos FA
Apr 22 2020 by John S. King, MD
72-year-old white male c/o of distortion OS for about 2 months. 20/100 OS, normotensive, small grey-green subretinal area just temporal to the optic disc. FA shows leakage c/w a ppcnvm; there is some SR and IR leakage as well as staining of peripheral drusen and some window defects from cobblestone. Avastin was adminstered.
Photographer: Asli Ahmed
Imaging device: CA
Condition/keywords: drusen, peripapillary choroidal neovascularization (PPCNVM)
-
 CHRPE & Myelinated RNFL
CHRPE & Myelinated RNFL
May 21 2020 by John S. King, MD
47-year-old white female, asymptomatic, sent to evaluate a scar OD. 20/40 cc, normotensive, examination significant for a flat, solitary lesion with pigmented borders and depigmented center with early lacunae forming, along with myeliated RNFL at the temporal edge of the lesion.
Photographer: Kay Dalby
Imaging device: Topcon
Condition/keywords: congenital hypertrophy of the retinal pigment epithelium (CHRPE), myelinated nerve fiber layer
-
 Carotid Artery Plaque
Carotid Artery Plaque
Sep 9 2020 by John S. King, MD
66-year-old white male, former smoker, with a history of femoral artery stent a plaque removal in 2017, triple bypass 2019 (at that time there was no high grade carotid stenosis), diabetes significant for SNPDR OD and PDR OS (NVD). He underwent PRP OS and two months later developed a vitreous hemorrhage and had a PPV OS. Early in the post-operative period vision dropped to LP due to acute CRAO with retinal embolus present. He was found to have progressed to high grade carotid stenosis (versus imaging 6 months ago) and a left carotid endarterectomy was performed (see picture of the large plaque) .
Condition/keywords: carotid artery occlusion
-
 Femoral Artery Plaque
Femoral Artery Plaque
Sep 9 2020 by John S. King, MD
66-year-old white male, former smoker, with a history of femoral artery stent a plaque removal in 2017 (see picture), triple bypass 2019 (at that time there was no high grade carotid stenosis), diabetes significant for SNPDR OD and PDR OS (NVD). He underwent PRP OS and two months later developed a vitreous hemorrhage and had a PPV OS. Early in the post-operative period vision dropped to LP due to acute CRAO with retinal embolus present. He was found to have progressed to high grade carotid stenosis (versus imaging 6 months ago) and a left carotid endarterectomy was performed . He had a picture of this plaque, and after I asked to use it for image bank, he also showed me this older picture of his femoral plaque.
Condition/keywords: atherosclerosis
-
 Circinate Ring
Circinate Ring
Aug 24 2012 by John S. King, MD
DR
Photographer: Kristin Konecki, OcuSight Eye Care Center, Rochester, NY
Condition/keywords: circinate ring
-
Circinate Ring OCT
Circinate Ring OCT
Aug 24 2012 by John S. King, MD
DR; hard exudate at edges of macular edema and are hyper-reflective with shadowing.
Photographer: Kristin Konecki, OcuSight Eye Care Center, Rochester, NY
Condition/keywords: circinate ring
-
 Diffuse Choroidal Melanoma OCT
Diffuse Choroidal Melanoma OCT
Aug 24 2012 by John S. King, MD
Photographer: Kristin Konecki, OcuSight Eye Care Center, Rochester, NY
-
 Diffuse Choroidal Melanoma OD
Diffuse Choroidal Melanoma OD
Aug 24 2012 by John S. King, MD
AF
Photographer: Kristin Konecki, OcuSight Eye Care Center, Rochester, NY
-
 Extra Macular CNV with Spontaneous Resolution
Extra Macular CNV with Spontaneous Resolution
Aug 24 2012 by John S. King, MD
Spontaneous resolution at the 4-month visit.
Photographer: Kristin Konecki, OcuSight Eye Care Center, Rochester, NY
Condition/keywords: choroidal neovascularization (CNV), spontaneous resolution
-
 Extra Macular CNV
Extra Macular CNV
Aug 24 2012 by John S. King, MD
P/C c mild VFD
Photographer: Kristin Konecki, OcuSight Eye Care Center, Rochester, NY
Condition/keywords: choroidal neovascularization (CNV)
-
 Multifocal Central Serous Chorioretinopathy OS
Multifocal Central Serous Chorioretinopathy OS
Aug 24 2012 by John S. King, MD
26 sec
Photographer: Kristin Konecki, OcuSight Eye Care Center, Rochester, NY
Condition/keywords: central serous chorioretinopathy (CSCR), multifocal central serous chorioretinopathy (CSCR)
-
 Multifocal Central Serous Chorioretinopathy
Multifocal Central Serous Chorioretinopathy
Aug 24 2012 by John S. King, MD
14 min Autoimmune Hepatitis; slowly tapering prednisone; lesions resolved with lfPDT, but could not download movie of the OCTs because file too large.
Photographer: Kristin Konecki, OcuSight Eye Care Center, Rochester, NY
Condition/keywords: central serous chorioretinopathy (CSCR), multifocal central serous chorioretinopathy (CSCR)
-
 Multifocal Central Serous Chorioretinopathy
Multifocal Central Serous Chorioretinopathy
Aug 24 2012 by John S. King, MD
AF
Condition/keywords: central serous chorioretinopathy (CSCR), multifocal central serous chorioretinopathy (CSCR)
-
 Multifocal CSCR
Multifocal CSCR
Aug 24 2012 by John S. King, MD
Photographer: Kristin Konecki, OcuSight Eye Care Center, Rochester, NY
Condition/keywords: multifocal central serous chorioretinopathy (CSCR)
-
 Optic Nerve Drusen
Optic Nerve Drusen
Aug 24 2012 by John S. King, MD
AF
Photographer: Kristin Konecki, OcuSight Eye Care Center, Rochester, NY
Condition/keywords: optic nerve drusen
-
 Optic Nerve Drusen
Optic Nerve Drusen
Aug 24 2012 by John S. King, MD
Photographer: Kristin Konecki, OcuSight Eye Care Center, Rochester, NY
-
 Sclerochoroidal Calcification AF
Sclerochoroidal Calcification AF
Aug 24 2012 by John S. King, MD
AF
Photographer: Kristin Konecki, OcuSight Eye Care Center, Rochester, NY
Condition/keywords: idiopathic sclerochoroidal calcification
-
 Sclerochoroidal Calcification
Sclerochoroidal Calcification
Aug 24 2012 by John S. King, MD
Idiopathic Sclerochoroidal Calcification
Photographer: Kristin Konecki, OcuSight Eye Care Center, Rochester, NY
Condition/keywords: idiopathic sclerochoroidal calcification
-
 PED_CSCAN
PED_CSCAN
Aug 27 2012 by John S. King, MD
C-Scan
Photographer: Kristin Konecki, OcuSight Eye Care Center, Rochester, NY
Imaging device: Cirrus
Condition/keywords: idiopathic serous detachment of the retinal pigment epithelium
-
 Idiopathic Serous Detachment of the RPE
Idiopathic Serous Detachment of the RPE
Aug 27 2012 by John S. King, MD
Photographer: Kristin Konecki, OcuSight Eye Care Center, Rochester, NY
Imaging device: Cirrus
Condition/keywords: idiopathic serous detachment of the retinal pigment epithelium
-
 Idiopathic Serous Detachment of the RPE
Idiopathic Serous Detachment of the RPE
Aug 27 2012 by John S. King, MD
Photographer: Kristin Konecki, OcuSight Eye Care Center, Rochester, NY
Condition/keywords: idiopathic serous detachment of the retinal pigment epithelium
-
 Idiopathic Serous Detachment of the RPE
Idiopathic Serous Detachment of the RPE
Aug 27 2012 by John S. King, MD
Photographer: Kristin Konecki, OcuSight Eye Care Center, Rochester, NY
Condition/keywords: idiopathic serous detachment of the retinal pigment epithelium
-
 Proliferative Diabetic Retinopathy
Proliferative Diabetic Retinopathy
Aug 27 2012 by John S. King, MD
Photographer: Kristin Konecki, OcuSight Eye Care Center, Rochester, NY
-
 Proliferative Diabetic Retinopathy
Proliferative Diabetic Retinopathy
Aug 27 2012 by John S. King, MD
Photographer: Kristin Konecki, OcuSight Eye Care Center, Rochester, NY
-
 Proliferative Diabetic Retinopathy
Proliferative Diabetic Retinopathy
Aug 27 2012 by John S. King, MD
Photographer: Kristin Konecki, OcuSight Eye Care Center, Rochester, NY
-
 Proliferative Diabetic Retinopathy
Proliferative Diabetic Retinopathy
Aug 27 2012 by John S. King, MD
Photographer: Kristin Konecki, OcuSight Eye Care Center, Rochester, NY

A project from the American Society of Retina Specialists